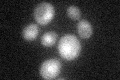
YDL132W
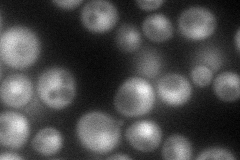
YDL132W
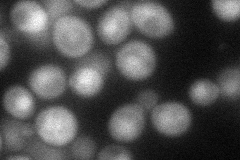
YDL132W
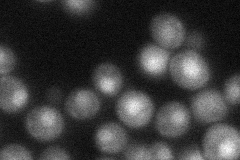
YDL132W

View description
Cullin, structural protein of SCF complexes (which also contain Skp1p, Cdc34p, Hrt1p and an F-box protein) involved in ubiquitination; SCF promotes the G1-S transition by targeting G1 cyclins and the Cln-CDK inhibitor Sic1p for degradation
Localization:
Intensity:
Fold change:
Significance:
-
C’ GFP library in SD
nucleus28 -
N' NOP1pr-GFP in SD
cytosol,nucleus96.7859 -
N' TEF2pr-mCherry in SD
nucleus50.0335 -
N' NATIVEpr-GFP in SD
nucleus44.1338 -
N' TEF2pr-VC and Cyto-VN in SD

#N/A0 -
C’ GFP library in SD+DTT

nucleus35.861.28No -
C’ GFP library in SD+H2O2

nucleus28.151No -
C’ GFP library in Starvation Media

nucleus23.450.83No -
C’ GFP library on the background of Pup2-DaMP

nucleus -
C’ GFP library on the background of CCT mutant

nucleus26.73870.95456No
